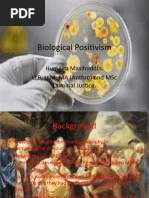

0% found this document useful (0 votes)
133 views7 pagesPositivism and Criminology in the Philippines
Sixto de los Angeles studied over 2,400 inmates at the Bilibid prison in Manila in the early 20th century, measuring their physical characteristics and comparing them to non-criminal populations in an effort to determine if criminality could be linked to biological factors, as Lombroso had theorized. While he found some differences in measurements, the data was not conclusive. Ultimately, de los Angeles concluded that cultural, moral, and environmental factors likely contributed more to criminality in the Philippines.
Uploaded by
Nicole BaysaCopyright
© © All Rights Reserved
We take content rights seriously. If you suspect this is your content, claim it here.
Available Formats
Download as DOCX, PDF, TXT or read online on Scribd
0% found this document useful (0 votes)
133 views7 pagesPositivism and Criminology in the Philippines
Sixto de los Angeles studied over 2,400 inmates at the Bilibid prison in Manila in the early 20th century, measuring their physical characteristics and comparing them to non-criminal populations in an effort to determine if criminality could be linked to biological factors, as Lombroso had theorized. While he found some differences in measurements, the data was not conclusive. Ultimately, de los Angeles concluded that cultural, moral, and environmental factors likely contributed more to criminality in the Philippines.
Uploaded by
Nicole BaysaCopyright
© © All Rights Reserved
We take content rights seriously. If you suspect this is your content, claim it here.
Available Formats
Download as DOCX, PDF, TXT or read online on Scribd
/ 7